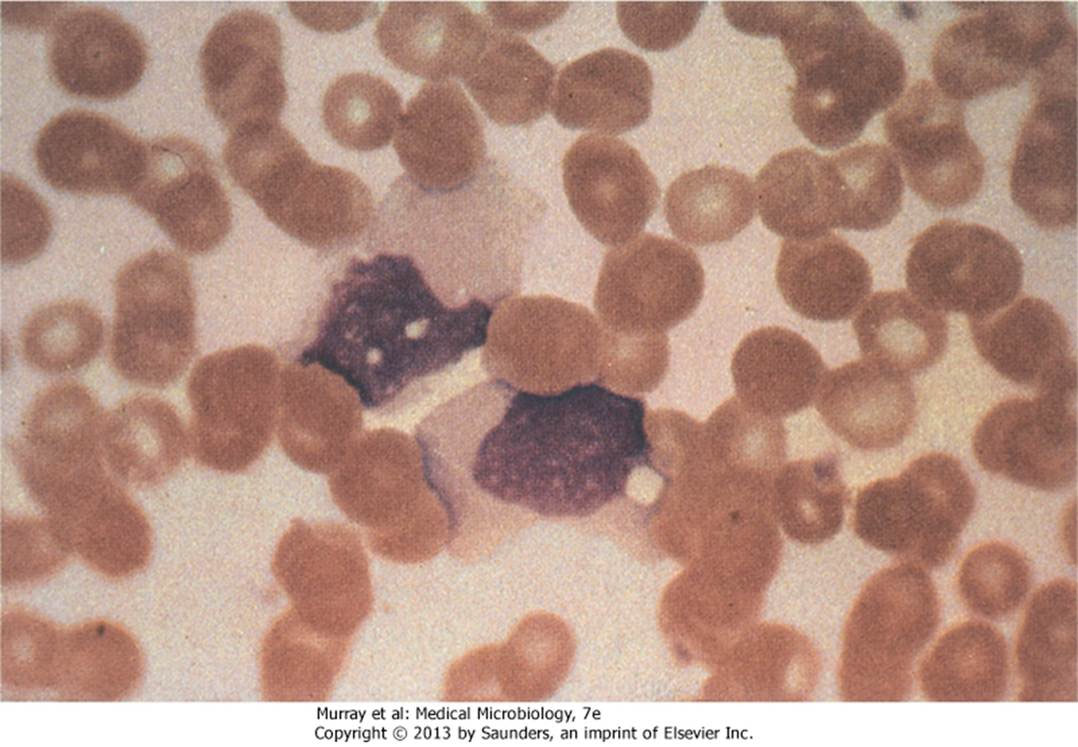

- 生科不考,沒教不考
- β-lactamases destroy
antibiotics such as penicillin

- Lipopolysaccharide (LPS)
- Lipid A 致病
- Core 含2-keto-3-
deoxy-octanoate(KDO)

- protoplasts

- mycolic acids(acid-fast):讓細菌不被 Gram-stained
Homologous recombination (同源) and Non-homologous recombination:
- 幾乎相同序列
- non- 需要酵素

- Intercalating agents (Chemical agents)
- Sex pilus 釣魚收線

- Generalized or Specialize
Positive
Negative
- 雙層膜
- Lipopolysaccharide (LPS)
- Peptidoglycan
- Fimbriae
- Antisepsis
- for 活體,化學
- Sterilization
- 燒毀!
- Disinfection
- 剩下 Spore
spore
只有
- Bacillus
- 好氧格蘭氏陽性桿菌
- Clostridium
- 厭氧格蘭氏陽性桿菌
- Alcohols
- non-enveloped viruses(沒外套膜)不能殺
- Spore, some fungi 不能殺
- Chlorhexidine (CHX)
- Triclosan
Disinfection and Sterilization
- Oxidizing
- 3-6% Disinfection
- 10-25% Sterilization
- Chlorine compounds
- Aldehydes
- Radiation
- 抗生素
- Protosil (Sulfanilamide)
- Penicillin
gram’s negative: Pili, Fimbriae


A.K.A Lipopolysaccharide (LPS)
- 可活化血小板及凝血系統為革蘭氏陰性菌造成敗血症的主因
- T independent
- B for bounding, A for action
都要背。。。

- Bacterial Capsules
- 莢膜,辨識不能

- Intracellular replication
- 躲進細胞

- β-lactamase 直接分解抗生素
- G(+)
- Spore 躲進Macrophage ,環遊世界
- Capsule: poly-D-glutamic acid
- 3 proteins
- Protective Antigen(PA83): B toxin
- Edema factor : 水腫, A toxin
- Lethal factor :致命,殺細胞,A toxin
- 2 exotoxin
- Edema toxin = PA63+EF
- Lethal toxin = PA63+LF
20不見了
Tip

- EF → cAMP
- cAMP 在腸道導致腹瀉
- 食物中毒
- Emetic form: 米,嘔吐,耐熱
- Diarrheal form: 其他,cAMP,不耐熱
- 大多無 Capsule
- 唯一宿主
- 被β 噬菌體感染才有毒
- AB toxin
- 抑制蛋白合成
- Capsule
- LPS 長一根 O antigen, Lipid A都是抗原
- G(-)
- Uropathogenic E. coli (UPEC)
- 泌尿道感染
- 溶血素(hemolysin, HlyA)
- Enterotoxigenic E. coli (ETEC)
- LT enterotoxin
- ST enterotoxin
- Enteropathogenic E. coli (EPEC)
- 沒有外毒素,黏著(BFP)導致拉肚子,爛
- type III 型分泌系統
- translocated intimin receptor (Tir)插入上皮細胞的細胞膜
- Tir 結合細胞Intimin receptor
- 使細胞表面喪失完整性
- LEE pathogenicity island
- Enteroaggregative E. coli (EAEC)
- 疊疊樂
- traveler’s diarrhea
- 慢性腹瀉(chronic diarrhea)和生長遲滯(growth retardation)
- Enterohemorrhagic E. coli (EHEC) / Shiga toxin producing E. coli (STEC)
- O157
- BFP, type III 型分泌系統
- 低燒,血便
- Hemolytic-uremic syndrome(HUS)
- (O157)
- enteroinvasive E. coli (EIEC)
- O124、O143、O164
- 藉由ActA 基因的actin-based motility
- 在細胞間伸出偽足流動(Listeria like)
- BFP
- plasmid-encoded bundle-forming pili
Shiga toxin
-
O (somatic) ; Vi (capsular); H (flagellar)
-
Capsule 能做疫苗 16S rRNA typing
-
毒力島I(pathogenicity island I)
- 位在細菌染色體上(bacterial chromosome)。
- 製造出Ssps 蛋白(salmonella-secreted invasion proteins)。
- Type III 型分泌系統。
-
毒力島II(pathogenicity island II)
- 位在細菌染色體(bacterial chromosome)。
- 躲避宿主免疫反應。
- 第二個III 型分泌系統。
- 分泌前列腺素(prostaglandin),並刺激cAMP 和體液分泌。
-
常潛伏在膽囊裡,造成慢性帶原
More than 2500 unique serotypes
- Salmonella enterica (serotype XXX)
Example
- Salmonella enterica serotype Typhi
→ S. Typhi (傷寒)
- Salmonella enterica serotype Typhimurine
→ S. Typhimurine (感染雞卵巢)
- 唯一宿主,高傳染性,10隻
- 口糞傳染
- Shiga toxin
- Plaque (鼠疫)
- 104隻
- 跳蚤、人傳人(肺部形,100%死亡)
- Type III 分泌系統
- 亂跑,Swarming
- Urease (+),產生胺,在膀胱

- 水裏,隨便長
- 好氧
- 侵犯傷口,綠,香
- 高抗藥
- 有 LasA 與LasB (都是elastase,會協同破壞elastin)
- exotoxin A
- 白色掏米水便,拉到膽汁來不及上色
- O1, O139
- 107 隻
- 帶有Cholera toxin 才致病,cAMP
- Microaerophilic (5% O2)
- 只吃portein
- 吃未熟的雞鴨牛羊肉
- Guillain-Barre syndrome (巴利氏症候群)
- 唯一宿主
- 子宮頸感染
- Fitz-Hugh-Cutis syndrome: burning with urination, vaginal discharge,vaginal bleeding) → pelvic inflammation → peritonitis, perihepatitis
- No Vaccine
- 武器:
- Pili
- IgA protease
- Endotoxin (lipooligasaccharide; LOS)
- Por proteins(Protein I, P.I)
- 破壞 endolysosomes (endosome+lysosome),鑽出來活在 neutrophils 中
- Opa proteins (Protein II, P.II)
- Rmp proteins (Protein III, P.III)
- Gram’s Positive
- Catalase 有氣泡 (區別 Streptococci)
- 兼性厭氧
- 高鹽生存
- Hyaluronidase
- DNase

- Portein A:抑制 IgG
- Cytotoxin: 破壞膜
- 全溶血(β hemolysis)
- Coagulase-postive (凝固酶陽性)
- Cytotoxin:
- α: 全溶血
- β: 水解磷脂
- δ: 介面活性劑
- γ and Panton-Valentine (P-V): 穿孔
- Exfoliative toxins (脫皮毒素)
- proteases
- ETA: heat stable, phage
- ETB: plasmid
- Enterotoxins A (Heat stable)
- Toxic shock syndrome toxin-1 (TSST-1)
- Coagulase
- fibrinogen 變成不可水解的 fibrin
- 保護菌體
- 疾病
- 菌血症 (Bacteremia)
- 肺炎 (Pneumonia and Empyema)
- 關節炎 (Septic arthritis)
- 骨髓炎 (Osteomyelitis)
Methicillin-resistant S. aureus (MRSA)
- β-lactam 抑制 PBP2A 合成細胞壁
- MRSA 產生受體結合 β-lactam
- S. epidermidis
- S. saprophyticus
- Catalase negative
- C-carbohydrate
- 兼性厭氧
- β-hemolysis
- Groop A Streptococci (GAS)
- Hyaluronic acid capsule (玻尿酸夾膜)
- M protein
- 用 emm gene 分類
- 抑制 C3b

- M-like proteins
- C5a peptidase
- Streptococcal pyogenic exotoxin (erythrogenic exotoxin, 化膿毒素)
- Streptolysins (hemolysins)
- Streptolysin S (SLS)
- Streptolysin O (SLO)
- Streptokinase
- 疾病
- pharyngitis (咽喉炎)
- Scarlet fever (猩紅熱)
- Pyoderma (impetigo;膿疱病)
- Erysipelas (丹毒)
- Cellulitis (蜂窩組織炎)
- Necrotizing fasciitis (壞死性筋膜炎)
- Bacteremia
- Puerperal sepsis
- Puerperal sepsis (產褥熱)
- Rheumatic fever (風濕熱)
- Acute glomerulonephritis (急性腎絲球腎炎)
- group B streptococci (GBS)
- β-hemolysis
- CAMP test postive (區分 group A, B)
- 疾病
- Meningitis and Sepsisin neonates (新生兒腦膜炎、敗血症)
- 陰道有,無症狀
-
只有 S. pneumoniae 高致病
-
α-hemolysin
-
疾病
- 蛀牙
- Subacute endocarditis (心內膜炎)
- 多重夾膜
- 做疫苗(PPV23, PCV13)

- IgA protease
- Pneumolysin
- Quellung (夾膜腫脹測試)
- 疾病
- 流感後肺炎
- Sinusitis (鼻竇炎)
- otitis media (中耳炎)
- Meningitis (腦膜炎)
- Bacteremia
- 長得像鍊球菌
- 高鹽、bile salt 生存
- 臨床
- Enterococcus faecalis (糞腸球菌, 75%)
- Enterococcus faecium (屎腸球菌, 20%)
- 疾病
- Urinary tract infections
- Peritoneal infections (腹膜感染)
- Bacteremia
- 需氧
- 長很慢(20hrs 分裂)
- 非典型G+
- 細胞壁含有過多的脂類,無法直接用水溶性染劑做染色
- carbolfuchsin 染,酸性酒精脫色
- acid fast stain +
- 不產生外毒素,靠免疫
- 細胞壁
- Mycolic acid
- Lipoarabinomannan(LAM)
- 類似 O antigen

-
Intracellular pathogen
- 鑽進 Macrophage
- 引發 TH1 分泌 IFN-γ,移除 Macrophage
- 太多 Macrophage 感染導致 Caseous necrosis (乾酪性壞死)
-
唯一宿主
-
檢測
- 痰液
- Tuberculin skin testing (TST)
- Interferon-γ release assays (IGRA)
- Microscopy
- acid-fast stain +
- 高特異性
- 慢(數月)
- PCR
-
藥
- Rifampin (RMP)
- Isoniazid (INH)
- Pyrazinamide (PZA)
- Ethambutol (EMB)

-
疫苗: BCG (牛型分枝桿菌)
-
Hansen’s Disease
-
唯一宿主
-
病徵
- Tuberculoid leprosy (類結核型)
- 觸覺喪失
- TH1,免疫強
- Lepromin skin test (+)
- Lepromatous leprosy (麻瘤型)
-
檢測
-
治療
- 無疫苗
- Sulfones
- Rifampin
- Clofazamine
- M. avium complex (鳥型分支桿菌,MAC)
- M. kansaii
- M. marinum
- M. ulcerans
- M. fortuitum complex (rapidly growing)
- Gram’s stain 染不上去的
- Weakly acid-fast stain
- 細胞壁含有 mycolic acid
- 好氧
- buffered charcoal yeast extract(BCYE) 培養基
- β-lactam 抗性
- Intracellular pathogen
- 呼吸傳染
- 症狀
- 厭氧
- Endogenous infection (自產自銷)
- ”臼齒“菌落
- 組織中毛毛邊界 (像黴菌),放射狀紫色條紋
- 兼性厭氧
- 莢膜
- 不吃 lactose
- 巧克力培養基
- Hemin (X factor)
- NAD (V factor)
- Type B strains 致病 (HiB)
- 有疫苗
- 莢膜上有 polyribitol phosphate (PRP)
- IgA proteases
- 疾病
- Meningitis (嬰幼兒腦膜炎)
- Epiglottitis (會厭炎)
- soft chancre / chancroid (軟性下
疳) in men
- subacute endocarditis (亞急性心內膜炎)
- 黏在呼吸道上皮細胞
- 只能人傳人
- 好氧
- Pertussis toxin
- AB toxin
- A: S1
- B: S2-S5

- 分期(菌量逐漸下降)
- Catarrhal phase (黏膜期)
- Paroxysmal phase (發作期)
- Convalescent phase (恢復期)
- 超難培養
- 疫苗
Francisella and Brucella(G-)
- chocolate, buffered charcoal yeast extract(BCYE) 培養基
- Intracellular pathogen
- Tularemia (兔熱病)
- 獵獵獵人
- Ulceroglandular (潰瘍腺, most common)
- Oculoglandular (眼腺, contamination of eye)
- Typhoidal (腸傷寒)
- Pneumonic
- Oropharyngeal and gastrointestinal diseases
- 常見
- Intracellular pathogen
- Intracellular pathogen
- 污染水源傳染
- 老人會演變成肺炎
- pontiac fever
- 難養到名字叫難養
- 抗生素濫用牙起來
- Antibiotic-associated diarrhea
- Toxin
- enterotoxin (toxin A)
- disrupt the tight cell-to-cell junction
- Cytotoxin (toxin B)
- 好大一隻
- 很多 toxin 分解組織(用以分類)
- Gas gangrene (氣性壞疽)
-
botulinum neurotoxin
- 不可逆切 SNARE , Acetylcholine 出不來
- flaccid paralysis (弛緩性麻痹)
-
嬰兒不能吃蜂蜜,可能有 C. botulinum
- 細得看不到
- Endoflagella
- 醣脂與脂蛋白外膜,無 LPS
- Chancre (無痛下疳,法文), Syphilis
- 無毒素,免疫
- 唯一宿主
- 對氧氣極度敏感(只能體液傳染)
- Penicillin
- Anticardiolipin Abs (rapid plasma reagin )
- 中間宿主: Ticks 蜱蟲
- Lyme disea
- Relapsing fever
- 發燒(3-7d)又不燒(7d),來來回回
- 肝脾腫大(splenomegaly and hepatomegaly)
- 寄生在腎臟
- 人畜共通
- 唯一可培養的螺旋體
- Weil disease
- 最小可以體外培養 (0.3-0.5μm)
- 除了 M. pneumoniae 好氧,都是兼性厭氧
- 無 peptidoglycan,用 Sterols 維持穩定(就他有)
非典
就很像 Mycoplasma
Chlamydia and Chlamydophila (批衣菌,G-)
- chlamydo: 外套
- 無 Peptidoglycan,有 LPS(很少)
- 絕對寄生
- 美國最盛行的性病
- 兩種型態
- Elementary body(EB): 傳播用
- Reticulate body(RB): 較大,細胞內生長繁殖
- Serovars (血清型)分類
- 疾病
- Trachoma (砂眼)
- 泌尿道感染
- Lymphogranuloma venereum (LGV ,性病)
- Serovars L1, L2, L3
- 輸軟管阻塞
- Fitz-Hugh-Cutis syndrome
- 治療
- doxycycline, azithromycin
- 非典
- Chlamydophila psittaci (鸚鵡熱)

- 斑疹傷寒
- 治療
- doxycycline, azithromycin
- 像 Chlamydia
- LPS
- Phase I
- Phase II
- O antigen 不見
- 反而有抗原性強,先測到 Ab
- Q fever
- Cotynebacterium diphtheria (白喉棒狀桿菌, G+)
- Mycobacterium tuberculosis
(TB)
- Mycobacterium leprae (痲瘋病)
- Typhoid Fever (傷寒)
- Shigella (赤痢)
- H. pylori (幽門螺旋桿菌)
- N. meningitidis (腦膜炎雙球菌)
- N. gonorrhoeae (淋病雙球菌,gonococcus)
- Bordetella pertussis (百日咳)
- Mycoplasma pneumoniae (肺炎黴漿菌)
- 好氧
- Bacillus
- Pseudomonas aeruginosa (綠膿桿菌)
- Legionella
- Bordetella pertussis (百日咳)
- Mycobacterium (分枝桿菌屬)
- Nocardia
- Mycoplasma pneumoniae(肺炎黴漿菌)
- Francisella
- Brucella
厭氧菌會產生 abscess (膿腫),Metronidazole 治療
- 厭氧
- Actinomyces (放線菌,G+)
- Cutibacterium(痤瘡丙酸桿菌,G+)
- Clostridium (梭狀桿菌,G+)
- 牙齒上G-
- Porphyromonas gingivalis (PG)
α hemolysin
Viridians Streptococci (草綠鏈球菌)
β
S. aureus
S. pyogenes (GAS)
S. agalactiae (GBS)
- Typhoid Fever (傷寒)
- Mtb and Nocardia
- Francisella and Brucella
- Legionella
- 亞急性心內膜炎
- Aggregatibacter actinomycetemcomitans (伴隨放線菌)
- Viridans Streptococci
- Staphylococcus epidermidis
- 感染性心內膜炎
- Streptococci sanguinis (血鏈球菌)
- Staphylococcus aureus
好氧
- Mycobacterium tuberculosis (肺結核)
- Nocardia
- Bordetella pertussis (百日咳)
- Legionella pneumophila
- Mycoplasma pneumoniae
- Haemophilus influenzae
- Streptococcus pneumoniae
進入血液需要莢膜,所以大部分(75%)的致病菌都擁有K1 莢膜抗原(K1 capsular antigen)
- Pseudomonas aeruginosa (綠膿桿菌)
- EIEC: 是敗血症最常見的革蘭氏陰性桿菌致病原。
- 所有沙門氏桿菌
- Neisseria
- Haemophilus influenza (流感嗜血桿菌)
- Bartonella: 反反覆覆
- Francisella
- Bacteroides fragilis: 菌血症最常見的厭氧菌病原
- Candidasis albicans
- 溶血性尿毒症候群(hemolytic uremic syndrome, HUS),
- 急性腎小球腎炎(acute glomerulonephritis)
- Streptococcus pyogenes (GAS)
- Streptococci pneumoniae
- Mycobacterium tuberculosis
- Hib
- Bordetella pertussis
- 噬菌體感染毒性
- O 抗原?其實不同種
- STEC: O157:H7
- 霍亂弧菌: O1, O139
- Penicillin (PCN)
- Cephalosporin
- Carbapenems: Imipenem, Meropenem, Ertapenem
- Monobactam: Aztreonam
機制
Peptidoglycan 形成時 Lys Ala 結合,Penicillin 類似Ala,卡住 Penicillin binding protein (PBPs)


- Vancomycin(萬古霉素)
- Teicoplanin
- Macrolide (巨環): Erythromycin, Azithromycin
- Lincosamide(林可胺): Clindamycin
- Oxazolidinones (噁唑烷酮): Linezolid
- Chloramphenical
- Aminoglycoside: Gentamicin, Tobramycin, Amikacin
- Tetracycline: Tetracycline(四環黴素), Doxycycline, Minocycline
- Glycylcyclines
- Quinolones
- Fluoroquinolone: Ciprofloxacin, Levofloxacin,
- Moxifloxacin
- Metronidazole
- Rifampin
- Mycobacterium tuberculosis(結核箘)有效
- 橘尿
- Sulfanilamide
- 類似PABA

- Trimethoprim
- Membrane
- Cell wall
- chitin
- β1,3 D-glucan
- mannan
### Hyphae
- Sepate hypha
- Coenocytic hypha
- Vegetative hyphae (營養菌絲)
- Aerial hyphae (空中菌絲)
-
Sexual spores
- Zygospore (接合孢子)
- Ascospore (子囊孢子)
-
Asexual spores
- Sporangiospores (孢子囊孢子)

- Blastospore (芽生孢子)
- Chlamydospore (厚膜孢子)

- Conidia (分生孢子)
- Arthrospore (分節孢子)
- Phialospore (瓶孢子)

- 有性: Ascospore
- 無性: Conidia, Arthrospore, Phialospore, Chlamydospore
- Hyphae 連接世代
- Ascus(n+n)→ Karyogamy(2n)→ Ascospore(n)
- Basidium(n+n → 2n) → basidiospore(n,有性)
- 沒無性胞子
- 產生Sporangiospores(孢子囊孢子)
- Zygospore (接合孢子)
- 絕對寄生
- No sexual spores
- Spore 注射進入細胞,青蛙下蛋、長出細胞膜,再炸一堆Spore
- 認 ergosterol接在膜上,穿孔
- Amphotericin B
- 強,七傷拳
Echinocandins
- cystine 類似物
- Amphotericin B 協同
- Grow inside the phagocytes

念珠菌(Candidasis)
- 白色念珠菌(C. albicans)
- 光滑念珠菌(C. glabrata)
- 第二好發
- 成人
- 抗生素抗性
- 不大產生 hyphae
- 近平滑念珠菌(C.parapsilosis)
- 熱帶念珠菌(C. tropicalis)
Candida albicans 白色念珠菌
- 70% 院內黴菌感染
- pseudomembranous candidiasis
- 紅斑性念珠菌感染(erythematous candidiasis)
- 口角炎(angular cheilitis)
- 中央菱形舌炎(median rhomboid glossitis)
- 假牙口腔炎(denture stomatitis)25
- Vulvovaginal candidiasis (外陰陰道念珠菌病)
嘴
- 無 hyphae
- Cryptococcus neoformans (新型隱球菌)
- 腦膜炎
- 小心鴿子
- 1,3-α-glucan
- 皮炎芽生菌(Blastomyces dermatitidis)
- 夾膜組織胞漿菌病(capsulatum Histoplasmosis)
- 副球黴菌病(Paracoccidioidomycosis)
- 瀰漫性疾病(disseminated disease) -> 影響腎上腺
- Histoplasmosis
- Paracoccidioidomycosis
- 胞內寄生
- Histoplasmosis
- Penicilliosis
鈣結合蛋白(calcium-binding protein)—CBP1,對於胞內寄生獲得鈣離子很重要。
- Ivanovski and Beijerinck 證明菸草疾病是病毒引起(1890s)
- 起源尚無定論
- 數量最多的微生物
- 參與了細菌、古菌、真核生物的演化
- 直徑 20~450nm
- 無套膜 -> 口糞傳染
- Capsomeres
- 組成 Capsids 蛋白質次單元
- 雙股環狀 DNA
- Bind p53, p105RB 基因 → immortalize (transform)
- p53
- Papilloma E6
- Polyoma T antigen
- p105RB
- Papilloma E7
- Polyoma T antigen
- 在表皮(1-4)、黏膜 (genital:6, 11)
- 接觸傳染
- dysplasia (不典型增生)
- Warts (疣)
- Cervical cancer (子宮頸癌)
- 促進 keratin (角蛋白) 產生 → epithelial spikes (papillomatosis)

- 檢測
- Pap smear 子宮抹片
- 巴潘尼克氏染色法( Papanicolaou stain )
- koilocytotic (一圈透明)

- 疫苗 (HPV-6, 11, 16, 18)
- SV40, BK, JC 沒在人身上造成癌症
- BK: kidney
- JC: Central nervous
- 實驗室讓細胞不停生長
- 免疫缺失患者身上:
- BK: 出血性膀胱炎(hemorrhagic cystitis; HC)
- JC: 攻擊 CNS 造成 Progressive multifocal leukoencephalopathy (PML)
- 雙股環狀 DNA
- Transformation (只在動物)
- E1A: bing pRB
- E1B: bind p53
- 呼吸、接觸傳染
- 症狀
- 最小 DNA 病毒 (18-26nm)
- 感染紅血球
- 只有 B19 造成人類疾病,十分普遍
- 第五熱、4 - 15 歲
- 呼吸傳染
-
製造 DNA polymerase
-
viral matrix proteins
- 病毒顆粒內
- 幫助本身 DNA 複製
- 躲免疫
- Tegument proteins
-
轉錄
- α: immediate-early (ie) protein
- β: early protein
- Transcription factors
- DNA polymerase
- γ: late protein
-
轉錄多樣性
- Direct repeats (照順序重複)
- Inverted repeats(逆向重複)
- Latency
- 潛伏
- LATs(Long-Term Antisense Transcripts)
- LATs 抑制病毒基因表達(轉錄因子、RNAi),維持潛伏期
- 細胞融合
- Mucoepithelial cells → Neuron
- thymidine kinase 啟動神經細胞合成 DNA
- 兩種
- HSV-1:
- HSV-2:
- 性傳染,感染下半身、新生兒疾病
- 骶骨或腰椎神經節(sacral or lumbar ganglia)
- viremia
- 疾病
- Encephalitis (腦炎)
- Cold sores(唇疱疹)
- Neonatal HSV: 新生兒死亡、神經殘疾
- Cytopathologic effects(CPE)
- 檢測
- Tzanck smear
- 也稱為水痘皮膚測試(Chickenpox skin test)、疱疹皮膚測試(herpes skin test)
- 找 Cowdry type A inclusion body
- 治療(針對 DNA polymerase)
- Acyclovir(ACV): guanosine 類似物
- Foscarnet (ex. Pyrophosphate mimic): 抑制病毒 DNA polymerase 上的 pyrophosphate binding site
- Mucoepithelial cells & T cell → Neuron
- 呼吸道、接觸
- 帶狀疱疹
- 沿著神經移動
- 透過 viremia(病毒血症) 到皮膚
- 水痘
- 治療: ACV、Famciclovir、Valacyclovir
- Reye syndrome:
- 發生在急性發熱性病毒感染後:水痘(varicella)、B型流感病毒和A 型流感病毒
- 兒童服用salicylates (aspirin)會增加風險(同Influenza virus)
- 產生伴有肝功能不全的急性腦炎(acute encephalitis)
- 活體疫苗(for kids)
- Latency: B cell
- 唾液傳染(Kiss disease) ,高盛行
- 疾病
- Infectious mononucleosis(傳染性單核白血球增生症)
- Burkitt’s lymphoma(伯基特氏淋巴瘤)
- Nasopharyngeal carcinoma (NPC,鼻咽癌)
- 檢測
- 嗜異性抗體(Heterophile Ab)
- 人類感染 EBV 時 B cell 生產
- 抗原: 動物血球
- Downey cell (Atypical lymphocytes)
- T cell 受 Heterophile Ab 刺激產生
- 具有更嗜鹼(深染)且空泡狀的細胞質
- 細胞核呈現腎形或葉形
- 邊緣因周圍紅血球作用而成鋸齒狀
- Monocyte、Lymphocyte、Epithelial cell → Monocyte、Lymphocyte
- 編碼IL-10 的結構類似物
- 最常造成先天缺陷(Congenital defects)的病毒
- 一般人感染沒事
- 免疫低下
- 視網膜炎(retinitis):脈絡膜視網膜炎(chorioretinitis)
- Oral ulcer
- Owl’s-Eye inclusion body
- 通常是病毒複製、繁殖的地方

- lymphocytes → T cell
- 疾病
- 嬰兒(常見) Exanthem subitum/Roseola(玫瑰疹)
- 一開始會持續發燒 acute febrile 約 4 天,但沒有其他感冒的症狀,之後 rash(疹子)跑出來後就會逐漸退燒。
- 成人
- 類似 mononucleosis 的症狀,或是淋巴腫、肝炎。
- 感染 B cell
- 為愛滋病(AIDS)患者最常感染的腫瘤病毒(Oncovirus)
- 接觸, saliva 傳染
- Varicella-zoster virus(VZ) 可以透過呼吸系統傳遞
-
最大的、構造最複雜(200x300nm)
- 自行攜帶所有 mRNA 合成所需的基因序列與蛋白質
- 可以編碼一些功能蛋白(Encodes proteins for function),例如:DNA 合成、核酸清除、躲避免疫反應的機制
-
呼吸道、結痂傳遞
-
局部性或全身性的膿包、發疹等,如天花、傳染性軟疣(molluscum contagiosum)
-
進入器官:如脾臟、肝骨髓或是其他淋巴結等,而產生膿皰(Pustules),因痘病毒感染而產生的膿皰非常明顯且容易辨認,此可以隔離人避免傳染。
-
病毒們
- Variola major(smallpox):大痘症(天花),嚴重可致死,1980 年消滅
- Variola minor(Alastrim):小痘症(類天花),比較沒那麼嚴重
- Vaccinia(牛痘病毒): 實驗室做出來當疫苗
- Cowpox(真牛痘病毒)
- Monkeypox(猴痘)
- Molluscum contagiosum(傳染性軟疣)
- cytolytic
- 宿主細胞裂解
-
糞口感染
-
高環境耐受
-
通常無症狀,不大會引起消化疾病
-
抗體對抗,只有 Poliovirus 疫苗
-
本土化
- Polio(以前)
- Enterovirus 71 (EV71)
- 攻擊神經
- 癱瘓、心肌(myocardial)炎、心包膜(pericardial)、無細菌腦膜炎(Aseptic meningitis)
-
HFMD: EV71, CAV A16
- 靈長類專一
- 不同程度症狀
- Asymptomatic (90%)
- Abortive poliomyelitis (非癱瘓)
- Paralytic poliomyelitis (1%)
- Post-poliomyelitis syndrome
- 診斷
- 糞便(stool specimens,好找)
- 喉嚨(swab specimens,most sensitive)
- 無 antivirals
- 疫苗
- 沙克 Salk: 去活性,肌肉皮下注射
- 沙賓 Sabi: 減毒活性,口服
向神經前進
- 溶解(cytolytic): 炸掉neurons
- 發芽(sprout): motor 倖存重生
- Post-polio syndrome: 新長的過勞,直接躺平 → degenerate, new weakness。
- Coxsackievirus A: 口咽小 水泡
- Coxsackievirus B: 全身
- 秋冬夢魘
- 呼吸道傳染,一般感冒主因
- 33 °C gg
- 怕酸
- ss RNA +
- 最大 RNA virus
- 透過 ER, gorgi 釋放
- 結構
- Spike (S)
- membrane glycoprotein(M)
- envelope protein (E)
- nucleocapsid protein (N)
- HAV, HEV
- 沒有套膜
- 糞口傳染
- 消化道 → 血 → 肝 → 膽汁 → 糞
- HBV、HCV、HDV
- 血液或相關體液
- B,D 的 sexual/ventral 高傳染
- 慢性病
- HDV
- 自然環境隨便活,耐熱 60°C
- 無症狀可傳染
- exocytosis
- 症狀 (小孩多無症狀,多能 self-limited)
- 肝細胞受損: 瀰漫性肝壞死和損害,局部淋巴結腫大、脾腫大
- Cholestasis (膽汁淤積): jaundice (黃疸)、hyperbilirubinemia (高膽紅素血症)。
- albumin 減少(復原不能)
- 檢測: anti-HAV IgM (症狀出現前 10 days)
-
Hepadnarvirus (肝病毒科)
- enveloped
- DNA virus
- Icosahedral(二十面體) capsid
-
有反轉錄酶
- RNA-dependent DNA polymerase
- 把做出來的 mRNA 變回 dsDNA
-
可以插入宿主 DNA

-
mRNA
- 3.5 kb mRNA
- HBcAg:黏 DNA capsid
- HBeAg:會被分泌出來,可用於檢驗血液傳染性
- 2.1 kb mRNA
- 2.4 kb mRNA
HBsAg: S, L, M
-
Incubation period :45~120 天。
-
慢性肝炎 → 肝受損 → 肝纖維化(fibrosis) → 肝硬化(cirrhosis) → hepatocellular carcinoma (HCC,肝細胞癌)
-
1985 有疫苗
- recombinant vaccine
- Subunit vaccine (第一代)
- S gene 的質體植入酵母 (第二代)
- 新生三劑
- 第一個疫苗預防的人類癌症
-
高傳染,20 億大盛行,3.5億慢性,其中65%中國,我們祖國真是太厲害了
- 亞洲剋星
- 健康成人89% 自己好,但孩童gg (30~90%慢性肝炎)
- Cell-mediated immunity (CTL) 很重要
- HBV 能夠在接觸到的表面存活約一週且仍具有 infectivity,如 table-tops、razor blades(剃刀片)、blood stains。
-
HBV 血液檢測
- 除了 HBcAg (黏在 capsid) 之外兩對半抗原抗體
- anti-HBs 才有保護作用
-
急性B肝
- Dane praticle: 完整構造
- Subviral praticle: 有抗原性空包彈
- window stage: HBsAg 驟降 → 測 anti-HBcAg
Subviral 很多(105),抓不到真的。
Subviral 可做疫苗(HBsAg)
- Flaviviridae (黃病毒科)
- 體外培養難
- 一次做一串蛋白質,再用 Protease 切,是個鋼彈模型玩家
- RNA 聚合酶(NS5B)
- E1, E2 表面醣蛋白具抗原性
-
中國和非洲盛行率高,我們祖國真是太厲害了
-
根B肝病情發展相似
-
換肝?沒用
-
三成自癒,七成 gg
-
初期無症狀
-
傳染
- 猩猩和人類only
- 性行爲傳染力不如 B肝
- 最主要由注射藥物(毒品)、刺青傳染。
-
診斷
-
目前 C 肝沒有疫苗
- viroid like virus
- 需要 HBV 表面抗原才能把自己包起來,自己做不出表面抗原
- ss circular RNA
- 類似 A 肝
- 會自己好
- 祖國強大了,祖國有疫苗
- Norwalk virus
- G Portein 引發 Endocytosis
- Receptor: AChR, NCAM
- Negri body
- 神經細胞質內病毒 inclusion bodies

- 疾病公衛
- 西班牙流感(1918): H1N1
- 人類流行:H1N1, H1N2, H3N2
- ss RNA (-)
- 很大顆,有套膜
- 結構
- nucleocapsid protein (N)
- polymerase (L)
- hemagglutinin-neuraminidase (HN)
- 無症狀傳染
- 只有 H,無 N
- 疾病
- rush (T cell 導致)
- Viremia
- CCC+P
- 咳嗽
- conjunctivitis(結膜炎)
- coryza(鼻炎)
- 畏光 (photophobia)
- Koplik’s spots
- 肺炎致死
- 疫苗 (MMR,1歲)
- measles
- mumps (腮腺炎)
- rubella
亞急性硬化性泛腦炎(Subacute sclerosing panencephalitis, SSPE)
- 缺陷變異的麻疹病毒持續感染腦部神經細胞,影響多個腦部區域(泛腦
炎panencephalitis)
- 症狀為人格、行為、認知、記憶的改變,出現肌躍型抽搐(myoclonic jerk)、失明、痙攣(spasticity),甚至演變到昏迷與死亡
- 可以在血液和腦脊髓液中檢測到高濃度的麻疹病毒抗體
- 顯微鏡下看到cowdry type A inclusion bodies
- 無症狀傳染
- 感染 15y 以下
- 腮腺對稱發炎
- 病毒血症 → 附睪(單側)
- 疫苗 (MMR,1歲)
- 2y ↓ 感染
- 不需要neuraminidase (NA)
- 抗體量少
- ambisense
- 一段RNA包含±序列
- 結構
- 沙: 很多 ribosome (無用)
- 2 ss circular RNA(-)
- 2 spikes
- ambisense
-
Asepitic meningitis
- Lymphocytic choriomeningitis virus (LCMV)
-
Lassa fever
- 人畜共通 , Robovirus (嚙齒類)
- 尿液、空氣傳播
- 很大顆 (130-14000nm)

- Receptor: Niemann-Pick C1 (NPC1)
-
Hemorrhagic rash

-
Ebola (伊波拉)
-budding 但殺死細胞
- 侵犯神經系統
- Arthropod-borne Virus (Arbovirus)
- Endocytosis
- ss RNA(+),有套膜
- 新生兒嚴重
- 一次感染,終身免疫
- 不會同時感染 PicoRNA
- 類似 Parvovirus ->
- 經過 ER, gorgi 釋放
- 造成rush, 腦炎, 黃疸(Yellow fever, black vomit)
- 病毒
- dengue virus (登革熱)
- Zika virus (茲卡)
- yellow fever virus
- West Nile virus
- Japanese encephalitis virus
Antibody-dependent enhancement (ADE)
- 抗體效價不足,反而促進病毒進入
- 抗體-病毒通過細胞表面的Fc受體進入宿主細胞。
-
白線斑蚊 (Aedes albopictus), 埃及斑蚊(Aedes aegypti)
-
偵測 NS1 protein
-
血小板減少
-
大出血 (相較於 Zika virus, Chikungunya)
-
ds RNA
-
double-layered capsids
- 20 面
- intermediate/ infectious subviral particle (ISVP)
- 中外層的capsid (σ3/VP7)在腸道被蛋白酶分解
- σ1/VP4 被切割產生 ISVP
- VP4 → VP5,VP8

-
無套膜
-
丟 RNA(+)出來做蛋白
Orthoreovirus 會感染人類,所以 Reoviruses 就是 Orthoreovirus,而 Reoviridae 指所有
- 11段 RNA
- 有疫苗(減毒)
- 疾病
- 嬰兒拉肚子,嚴重水洩
- 小腸絨毛變短變鈍
- 嘔吐、腹瀉、發燒和脫水
- 腸胃道及呼吸道症狀?
-
脊椎及非脊椎動物共通
- Colorado tick fever (科羅拉多壁蝨熱)
- tick-borne viral disease (壁蝨傳播病毒疾病)
-
疾病
- Envelope Glycoprotein
- TM (gp41):穿膜
- SU (gp120):整天突變,騙抗體用的,高度糖化,接 CD4
- Nucleocapsid core
- CA (p24):capsid
- Integrase: 病毒與宿主 DNA 整合
- Reverse transcriptase/RT (模板 RNA 3 → 5)
- tRNAs: 反轉錄引子
- 兩條相同 ss RNA(+)
- 結構基因
- GAG(Group-specific antigen):Core,Capsid protein
- POL(Polymerase):RT, Protease, Integrase
- ENV(Envelope):SU(gp120)
- 附屬基因
- tax, tat:活化轉錄(Transactivate)病毒和細胞基因
- rex, rev:調控RNA splicing和促進RNA片段釋出到細胞質
- nef:減少TH的CD4,促進T細胞活化
-
Protease cleavage
-
Life cycle of HIV
- gp120 結合 CD4及 Chemokine co-receptor
- M tropic(R5):結合CD4與CCR5 , 感染Monocyte、Macrophage、Dendritic cell、已活化的T cell等(前期)
- T tropic(X4):結合CD4與CXCR4 ,感染 Th cell(後期)
- gp41插入細胞膜
- RT 出 Provirus(ds circular DNA )
- Integrase 插 Provirus 進宿主
-
篩檢,測 p24
- ELISA
- Western blot analysis
-
治療
- 抑制Reverse transcription
- Azidothymidine/AZT: Thymidine 類似物
- Highly active antiretroviral therapy/HAART(雞尾酒療法)
- 癌症及神經疾病相關。
- 四種型態
- A: 未成熟的病毒顆粒
- B: Mouse mammary tumor virus
- C: HTLV-1, 2, 5(人類) , Rous sarcoma virus(鳥禽類)
- D: Mason-Pfizer monkey virus
- 潛伏期長,需長時間發病、死亡。
- 造成神經系統疾病及免疫抑制。
- Type D相似。
- HIV-1、HIV-2
- 無明顯症狀
- Foamy cytopathology
- 插入人類基因組
- 例子:Human placental virus
- 無活性疫苗: 霍亂、百日咳、日本腦炎、狂犬、A流、傷寒、沙克 (霍!百日狂A流,傷害很SUCK )
High endothelial venules
- 看管淋巴細胞進入血管
- 認 L slectine ,成熟不表現

- Germinal center
- Memory B cell
- FDCS
- Macrophage
- PAMPs
- 病原相關分子樣式(Pathogen-Associated Molecular Pattern)。是指病原體上普遍表現的、可以引發先天性免疫的微小單位。
- DAMPs
- 損傷相關分子樣式(damage-associated molecular patterns, DAMPs)。指自身細胞受損或死亡後產生的物質,也可以被先天免疫系統認出。
- PRRs
- 給 PAMPs 或DAMPs 結合的細胞受體
3,7,8,9 → 病毒
2/6, 2/1, 4, 5 &→ 發炎
-
NFκB pathway (外生性)
- MyD88, TRAF6 主導
- NEMO (Nuclear factor-kappa B Essential Modulator)
- 產生 IL-1β
-
TLR-3
- TRIF, TRAF 3 主導
- 抗病毒,啟動 type 1 Interferon gene
-
TLR-7, 8, 9
- MyD88, IRF7
- 抗病毒,啟動 type 1 Interferon gene
-
TLR-2/6
- Porphyromonas gingivalis (G-, 厭氧) 的 LPS, LTA (lipoteichoic acid,脂壁酸)
- RIG-I-like receptors (RLRs)
- RIG-I: dsRNA
- MDA-5: dsDNA
- NOD-like receptor (NLRs)
- NOD1: G(-)的細胞壁
- NOD2: 大部分細菌的醣蛋白
- NLRP: 發炎小體(inflammasome)
inflammasome
- NLRP3、ASC、pro-caspase 1合稱inflammasome
- pro-caspase 1 切割 pro-IL-1β 產生 IL-1β
- 造成
- 急性細胞激素(cytokine) 釋放出細胞外
- 細胞焦亡(pyroptosis)
- Stimulator of interferon genes (STING)
- ER 上
- 偵測 dsDNA:cGAS(cyclic GMP-AMP synthase)轉換
- 偵測細菌的第二傳訊者
肝臟製造,血液中
- Lysis 溶解
- Chemotaxis 趨化
- Opsonization 調理

- C3b, C4b
- 結合 Ig
Factor I 和 CR1 會切斷 iC3b,形成 C3c和 C3dg,而 C3dg 會由CR2 辨認。
- CR1
- CR2: B cell, EBV(Epstein-Barr virus) receptor
- CR3, 4
- CR3 是 integrin
- C5a>C3a>>C4a
- 紅腫熱痛
- 可能結合肥大細胞(發炎)
- 不同 pathway 產成C3轉化酶(C4b2a, C3bBb, C3(H2O)Bb)
- c3轉化酶 + C3b = 切 C5
- C5b, 6, 7, 8, 9 形成 Membrane attack complex(MAC)
- C1q 辨識 Ag,六顆球抓 Ag
- C1r互相活化
- C1r 活化 C1s
- 產生 C4b2a
- Mannose-binding lectin(MBL) 直接認糖類抗原
- 產生 C4b2a
factor D 切 B 留下 Bb
- C3b 開始
- C3b+B=C3bB
- C3bB (D)→ C3bBb
- C3bBb 沈積在病原體表面
- C3 水解成 C3(H2O)開始
- C3(H2O)+B (D)→ C3(H2O)Bb
- C1-INH: C1qr2s2
- Factor I/MCP: 切割C3b → iC3b + C3f
- DAF: C3轉化酶 (C3bBb、C4b2a)
- CD59、S protein: MAC
- 特殊顆粒(specific granule)
- 多數
- lysozyme,collagenase,elastase
- 嗜苯胺藍顆粒(azurophilic granule)
- azure A dye 染色
- 骨髓過氧化酵素(myeloperoxidase)
- 防禦素(defensin)
- IgE receptor
- high-affinity IgE receptor(FcεRI)
- 組織少見
- 幹細胞因子(c-KIT ligand, CD117)為促進成熟
- 血液少見,組織常見
- 很多高親和力受體
- high-affinity IgE receptor(FcεRI)
-
MHC II
-
依照來源
- Monocyte-derived macrophages
- bone marrow derived
- 出生後,前驅細胞受單核球/巨噬細胞集落刺激因子(monocyte/macrophage colony-stimulating factor, M-CSF)刺激
- 進入血液,壽命約 1~7天。
- Long-lived Tissue-resident macrophage
- yolk sac or fetal liver derived
- 擁有自我更新能力(self-renewal capacity)以維持數量。
- 不同的器官不同的表型(phenotypes)
-
依照功能
- 非典型(nonclassical monocyte, M2)
- 典型/發炎型(classical or inflammatory monocytes, M1)
- CD 14 (Toll-Like receptor, 認 LPS )
- 分泌 TNF-α
- 辨認抗原
- Mannose receptor

- Dectin-1
- 辨認真菌細胞壁的 β-1,3-linked glucans
- CD11b

- SIRPα
- 黏附到健康細胞上的 CD47,產生「不要吃我」的信號
-
FLT3L 刺激發育
-
CD11c 表現
-
依照發育來源分為四種
- cDCs(Classical, conventional)
- 抓抗原,沿著淋巴跑
- PRRs
- Receptor
- DC-SIGN: 甘露糖(mannose)和岩藻糖(fucose)
- Dectin: 真菌細胞壁表現的 β-1,3-linked glucans
- CR
- 1 → naive CD8+ T cell
- 2 → CD4+ T cell
- pDCs (Plasmacytoid)
- 大ER
- 分泌 IFN-α
- TLR-1, 7, 9
- 血液傳染性病原體(blood borne microbes),帶到脾臟呈現 (先天)
- MoDCs (Monocyte-derived)
- 功能類似 cDCs
- 表現monocyte marker
- 發炎
- 蘭格漢細胞(Langerhans cells)
-
APC
-
NK 細胞佔了血液和脾臟淋巴細胞的 5~20%
-
抓 MHC I 不表現的
- NK receptor 傳遞殺了我

-
NKG2D
-
先天性免疫
- 被刺激:IL-12、IL-15、IL-18、IFN-α
- 分泌: IFN-γ
-
IgGr
- CD94 認 HLA-E
- KIR 認 MHC Ia (HLA-A, B, C)
- ITIM 傳遞抑制訊息
- K
- lysine
Info
- ITIM
- immunoreceptor tyrosine inhibitory motif
- HLA E
- human leukocyte antigen E,一種 MHC I ,一般的MHC I 呈現抗原,HLA E 呈現製造 MHC I 剩下的垃圾。

- Fas ligang
- 有毒的 Cytokines
- tumor necrosis factor (TNF)
- lymphotoxin (LT)
- Granules
- 先 Perforin 穿孔,再送granzymes導致凋亡
- 辨識特殊 MHC I: CD1d
- 活化分泌 IL4
- NKT v.s. TCR
- 都在胸腺成長
- NKT 表現多樣性較低的 TCR (limited repertoire TCR)
- NKT 辨識低抗原性的 lipid, glycolipid, hydrophobic peptide
NK v.s. NKT
- APC
- 成熟會被引到淋巴結的 BUFF
- 分類
- Marginal zone B cell
- B1
- from fetal liver
- 先天
- 認 Polysaccharide
- B2
- 先做 H chain, Ig α, β
- 再來 κ 失敗則 λ
- 能做 IgM. IgD
- 布魯頓酪氨酸激酶 Bruton tyrosine kinase, BTK
common lymphoid progenitor(CLP) → pro B VDJ重組 pre B VJ重組 immature B cell
- Plasma cell
- 漿細胞
- Complement activation
- Opsonization
- Nuetralization
- Light: κ, λ
- Heavy: μ(IgM), γ(IgG), α(IgA), δ(IgD), ε(IgE)
- Pre-B 完成 Heavy chain
- Immature B 完成 Light chain
- 首次遇到丟 IgM
- Class switch
- 五連體
- 四個 C domain → 不用 Hinge
- 很大支,主要在血管 10%
- 活化 C1
- 血漿總數 80%,總蛋白 75%
- G1-G4 差在 Hinge 長度
- 多產 70-75%
- G1 66%
- G2 23%
- G3 7%
- G4 4%
- 2nd immune responses
- 高穿透力 (唯一能過胎盤)
- 活化 C1
- Dimer (20% of IgA in human)
- J chain 串聯
- Compoment 黏在上面
- IgA 會去有黏液的腔室, Complement 能保護

- 在哪?
- IgA1: 鼻腔、淚水、唾液與母乳
- IgE: Colon
- 初乳, 母乳, 口水
- Secretory component (SC) 由黏膜上皮製造
- 腸道(Peyer’s patches)
- 四個 C domain → 不用 Hinge
- 亂分泌、亂黏Mastcell 的 Fc receptor → 去顆粒,發炎
- 雙重辨識: MHC, Peptide 都對才殺
- CD4 and CD8 are T cell co-receptors
- 表面一定有 CD3
- DiGeorge syndrome
- 胸腺發育不全

- CD3 具有 ITAM ,傳遞活化訊息
- 磷酸化則 ITAM activate
- 6 個分子:ζζ、εδ、γε
- αβ 主導後天,γδ主導先天
- γδ 無 Positive and negative selection
- 多為double negative T-cell,不會辨識MHC。
Positive (Stage 1)
- Cortical epithelial cell
- 是否會和 MHC 結合?會就存活。
Negative (Stage 2)
- 交界處或近髓質的 dendritic cell
- 是否結合自我抗原?是就死亡。
胸線
- Cortex
- Medulla
- dendritic cell
- medullary epithelial cell
- Dendritic cells(co-stimulatory activity)
- 呈現 B7 活化native CD8 TC
- Dendritic cells 分泌IL-12、IL-18 → CD8 TC 產生IFN-γ → 活化macrophage
-
- 藉由 CD4 effector cells:同前面所提,CD4 TH cell 會co-simulation
(1) 強化 Dentrictic cells(或APC)上的4-1BBL 去接上CD8 TC cell 的4-1BB,
以及B7 去接T cell 上的CD28。
(2) 同時分泌 IL-2 到CD8 TC cell。
- 定義:胸腺釋出且尚未接觸抗原
- 表面標誌:
- CD45RA
- CD62L 和 CCR7
- LFA-1/αLβ2(Lymphocytefunction-associated antigen 1)
- 次級淋巴器官
- Naïve T cell 被 APC 激活
- 表面標誌:
- CD25(IL-2 受體α鏈)
- CD69 (組織存活)和 CD40L,並且表達 CD45RO。
- 開始增殖並分化成不同亞型的效應 T 細胞(如 Th1、Th2、Th17、Treg)
- Activated CD4 T 分化而來,具備執行特定免疫功能的細胞。
- 只能選一條路走 (拮抗)
- 殺細菌
- IFN-γ,CD40/CD40L 活化 Macrophage → M1(吞噬特化)
- 寄生蟲 (嗜酸)
- M2 Macrophage 啟動修復
- 促進 neutrophils 產生
- IL-17
- 骨髓的基質細胞(stromal cell)和髓細胞(myeloid cell)產生G-CSF →嗜中性球(neutrophils)。
- IL-22
- IL-17、IL-22 促進上皮細胞產生抗微生物蛋白(antimicrobial peptides)。
- 殺胞外細菌和真菌。

-
停止表現活化受器,如:CD69
-
CD4 存活
-
CD8 存活
-
Central memory T cell (TCM)
-
Effector memory T cell (TEM)
- β1, β2(integrin):
- 周邊組織
- 快速成熟,血液遷移
- IFN-γ、IL-4、IL-5
-
Tissue-resident memory T cell (TRM)
- 誘導免疫細胞其移動
- selectin
- Integrins
- Immunoglobulin Superfamily
粗體: Effector T
TNF-α或LPS 也會刺激內皮產生 selectin
- neutrophils integrin 結合內皮細胞
- LFA-1 和 CR3 結合到内皮細
胞的ICAM-1 和ICAM-2。
- IL-8 改變構型,緊密結合
鑽過基底膜
- PECAM(CD31)
- Platelet endothelial cell adhesion molecule
- 血球和內皮細胞的細胞間隙
- Intergin (LFA-1, CR3) 結合到 PECAM
- 趨化素(chemokine)
- 組織中 Macrophage 分泌
- CXCL8: neutrophils
- CCL2: monocyte (CCR2)
graph TD
m[Macrophage]
d[Dendritic]
m & d---->12[IL12]-->nk[NK]-->|"IFN-γ"|m1[Macrophage]
12-->|"IFN-γ"|th1[Th1]-->|"IFN-γ"|m1
m & d ---->6[IL6]-->c[調理]-->ep[急性蛋白]
c-->t17[Th17, Tfh]
prr[PRRs]---> k -->1[IL-1]--->m1
m-->al["TNFα"]-->|聚集 TRAF|k["NFκ"B]
d-->ia["IFNα"]-->nk[NK]
18[IL18]-->nk
inflammasome[inflammasome]---->1 & 18
1 & 6 & ia-->Li[Liver] --> cr[C-reactive protien]
- 只有 dendritic cell 能活化 T cell
- APC可以暴露在某些微生物的產物,增強抗原呈現的能力,這種東西稱為佐劑(adjuvants)。
CCL19, 21 吸引 CCR7
- TLR signaling: 活化 DCs 表現 CCR7
- HEVs 表現 CCL21 吸引 DCs
- DCs 進入 HEVs
- CCL21 結合 CCR7 刺激 B7、增加 MHC
- DCs 是一次性的
- long-lived MHC I, MHC II
- co-stimulatory molecules
- 如醣蛋白, B7.1(CD80), B7.2(CD86)。
- 表現大量黏附因子,如 DC-SIGN、ICAM-1、ICAM-2、LFA-1、CD58。
- 分泌趨化素 CCL19:吸引初始 T 細胞與 DCs 鍵結。
- HEVs
- lymph node High endothelial venules
- Adhesion
- Ag-specific activation (primary signal)
- Costimulation
(second signal)
- Cytokine signals (third signal)
- T cell 的 LFA 先結合 APC 的 ICAM 1 (弱)
primary signal match ?
LFA-1 拉近
- LFA
- Lymphocyte function-associated antigen
- ICAM
- intercellular adhesion molecule
APC, 確認專一性
- CD4-MHC II → Lck 磷酸化 ITAM
- Lck
- Lymphocyte-specific protein tyrosine kinase
敵我辨識
- 活化的 activated CD4 T cell 不需要,因為 Macrophage, B cell 沒 B7
- Cytokines 導致分化
- TGF-β → 抑制

- β ~ H, α ~ L
- T cell 多樣性較高
- 在 secondary lymphoid tissues
-
可變段(V)、多樣段(D)以及連接段(J)
-
輕鏈沒有D
-
過程
- 重組訊號序列(recombination signal sequences, RSSs)做為切割位
- 重組活化基因(recombination activating gene, RAG) 只表現在發育中(完全未成熟)的B 細
胞和T細胞,切 DNA
- KU70 和KU80 夾斷裂端,形成髮夾
- ARTEMIS 打開髮夾,形成單股
- DNA 依賴型蛋白激酶(DNA-dependent protein kinase, DNA-PK) 修復單股,再加東西
- TdT(末端脫氧核苷酸轉移酶terminal deoxynucleotidyl transferase)會繼續隨機插入
-
Germinal center 中的 B cell 進行V-region 突變
-
根 Dendritic cell 搶, Affinity 高存活
-
T cell 的 IL 4, CD40/CD40L 觸發
- AID
- Activation-induced cytidine deaminase
- CD 前面沒有剪接點 → 變不出 IgD
- V-D-J 後面接要的類型
T-independent and dependent antigens
- 根據抗原需不需要 TFH 加持
- 一般非蛋白質抗原都是 T-independent
- T 一開始就做超多,B要透過 Affinity maturation, Isotype switch 強化
- IgM 半衰期短,親和力差,但是效率高
- 有核就有 MHC I
- MHC II α chain 沒有多形性 (polymorphism)
- MHC I: 8-10 胺基酸
- MHC II 13-25 胺基酸
- MHC I α chain 在ER 製造,calnexin 幫助組裝
- MHC I α:β2 形成, calnexin 放手
- calreticulin, ERp57不讓MCH結合
- Tapsin 幫助結合 TAP (transporter associated with antigen processing)
- Proteasome 打爛 protein,餵給 MHC,TAP 審查肽鍊長度(8-16 → 8-10)
- 運輸到細胞膜
- TCR 和 α3 結合
- protein 先被 endosome/lysosome 打爛
- Li 在 ER 卡著 MHC
- 丟出 endosome,和 lysosome 結合
- 酸性下LIP10水解,CLIP 繼續卡
- HLA-DM 解開 CLIP
- TCR 結合 β2
- Li
- 恆定鏈, invariant chain,CD74

CDRs
- CDRs
- Complementarity-Determining Regions
- 對細胞壓力(cellular stress)產生反應
- 活化NK cell 的NKG2D 受體
- MHC class I-like gene
- 並非第6 對染色體的MHC 基因區域,稱為 CD1
- 製造像 MHC I (ER, TAP )
- 作用像 MHC II (endosome/lysosome)
- CD1a、CD1b、CD1c
- 結合各種微生物的醣脂質(microbial glycolipids)、磷脂質、脂肽類等作為抗原
- 分枝桿菌的mycolic acid、glucose monomycolate、phosphoinositol mannosides、lipoarabinomannan
- CD1a 在Langerhans cell表現(還會表現CD207)
- 只有 CD1d
- 結合自身的脂質抗原(self lipid antigens)
- sphingolipids 和diacylglycerols
- CD1d 限制型T細胞(CD1d-restricted T cells),表現多樣性較低,會表達自然殺手細胞的受體,因此又稱作恆定型自然殺手T細胞(invariant NKT (iNKT) cells)。
- IFN-α
- Dendritic cell 分泌 (pDCs)
- Macrophage, B cell 分泌
- 活化 MHC I
- 促進 NK 分泌 IFN-γ
- IFN-β
- fibroblast 分泌
- 活化 MHC I
- 促進膠原蛋白的合成
- IFN-γ
- TH1, TC, NK分泌
- 活化macrophage(M1)
- Isotype switching
- TH2, TFH 分泌 (TH 主導)
- Isotype switching
- 單核吞噬細胞、樹突狀細胞、血管內皮細胞、纖維母細胞分泌
- 分化TFH, TH17 (Third signal)
- TNF-α, IL-1β, IL-6
- 促進漿細胞的生存。
- Chemokin 功能,非 IL
- 改變 integrin 構型改變,和ICAM-1、ICAM-2 形成更加緊密的結合
- 刺激 PMN,分泌 MMPs
- Treg 分泌
- 抑制所有免疫反應
- 刺激膠原蛋白的合成
- Dendritic cells, Macrophage 分泌
- 分化 TH1,分泌 IFN-γ
- 分化 CD8+ T細胞成CTLs。
- 促進 NK,分泌 IFN-γ
- NK 成長因子,類似IL-2
- 促進NK細胞生產IFN-γ
- 促進 CD8 T, NK 存活
- IL-17
- TH17 分泌
- 促進骨髓產 Neutrophils
- 上皮細胞產抗菌蛋白
- IL-22
- TFH 分泌,促進 B cell Isotype switching
Transforming growth factor
- 分化 TH17, Treg
- Isotype switching
發炎
tumor necrosis factor
- Macrophage 製造
- NK cell 釋放殺細胞
- IL6 發炎
- TNF-α, IL-1β, IL-6 acute phase response
- TNF-α 刺激內皮產生 selectin
- TNF 受器:type I (TNFRI)、type II (TNFRII) 可以聚集TNF receptor–associated factors (TRAFs)
刺激 dendritic cell 發育
- Toll-Like receptor
- Macrophage 認 LPS
- Sialyl-LewisX
- 表現:Neutrophils
- IgG Fc receptor
- 表現: B cell、濾泡樹突細胞、NK、Macrophage、酸中鹼、血小板和肥大細胞
- B cell Pax5 表現CD19, Igα, B cell linker protein(BLNK)
- CD 27
- 屬於 TNF receptor
- 大多數T細胞、部分B細胞和NK細胞上
- 促進 T cell 活化與存活
- 維持記憶 B cell
- CD70
- 位置:CD4 T cell
- Dendritic cells 呈現很多B7 活化 Tc
- Second signal
- 淋巴球表現
- CD45RO: Activator, Effector T cell
- CD45RA: Naive T cell
- Macrophage SIRPα
- 黏附到健康細胞上的 CD47,產生「不要吃我」的信號
- ICAM
- intercellular adhesion molecule, 黏附因子
NK
- 癌胚抗原(carcinoembryonic antigen, CEA)
- 妊娠的前兩個孕期(trimesters)時可見於腸道、胰臟和肝臟的細胞
- 許多上皮相關癌症表現量會增加
- B7
- DCs Marker
- second signal
- CD94/NKG2A
- NK cell inhibitory receptor
- 認 HLA-E (呈現MHC 渣渣)
- Fas
- 細胞凋亡開關
- NK cell Fas ligang 接上去殺細胞
- 幹細胞因子(c-KIT ligand)
- Mast cell 表現
- Syndecan-1
- 帶 B cell 回到骨髓
- Plasma cell marker
- 四大機制
- Release of Sequestered Antigen(孤立抗原的釋放)
- Molecular mimicry(分子擬態)
- Inappropriate expression of class II MHC molecules(第二類MHC分子不正常表現)
- Polyclonal B cell activation(多株B細胞活化)
- B cell 發瘋 (無 class switch)
- X-linked agammaglobulinemia (X-LA)
- 性聯(隱性)遺傳無丙型球蛋白血症
- B cell無法發育成熟
- Btk基因缺陷 (Bruton’s tyrosine kinase)
- Immunodeficiency with increased IgM (HIgM)
- IgM增加性免疫缺損
- B cell無法 class switching
- X染色體上 T cell CD40L 基因缺陷
- 容易製造IgM自體抗體
- Severe Combined ImmunoDeficiency (SCID)
- 重度複合免疫不全症
- 胸腺發育不成熟, 缺乏T cell
- X染色體上γ chain基因缺失,cytokine receptors 失能
- Wiskott-Aldrich syndrome (WAS)
- 抗體產量異常:IgA,E↑,IgG-,IgM↓
- 血小板小、少、爛
- X染色體上CD43基因缺陷
- MHC II > MHC I
- CD4 T > CD8 T
- Cyclosporin A(CsA)
- 免疫抑制劑(Immunosuppressants)
- 抑制 T cell
- 抑制IL-2的產生
- 抑制Ca2+-dependent 傳訊機制,以抑制細胞凋亡(作用於細胞內)
-
半乳糖存在的情況下 Fn, Pg, Tf 共凝集
-
caries
- Pit and fissure: S. mutans, S. sanguinis, Lactobacillus, Actinomyces
- Smooth surface: S. mutans, S. salivarius
- Root: A. viscosus, A. naeslundii
- Deep lesions: Lactobacillus, A. viscosus, A. naeslundii, S. mutans, Rothia, Propionibacterium, Arachnia, Eubacterium
-
黏附
- S. mutans: Antigen I/III
- Streptococcus parasanguinis (副血鍊球): Fap 1
- Actinomyces oris: fimbriae
- type1: tooth surface
- type2: epithelial cell surface
- Streptococcus gordonii: CshA